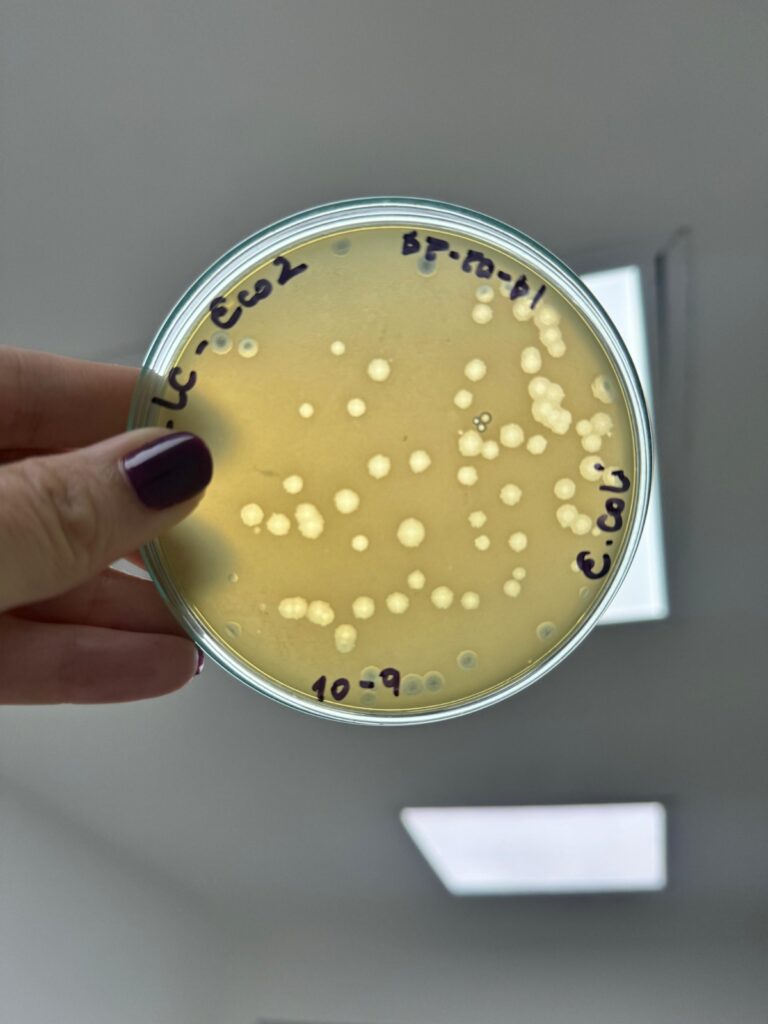

Una alianza estratégica entre el Ministerio de Ciencia, Tecnología e Innovación (MinCiencias) y la Universidad de Córdoba está transformando la industria quesera regional con la entrega de una innovadora biotecnología a 200 productores de queso costeño en Lorica, Planeta Rica, Chimá, Cereté, Tierralta y Ciénaga de Oro.
El bioproducto UNICOR_HM-QL, un bacteriófago polivalente pulverizado y encapsulado, representa un avance científico que ahora está al servicio de los pequeños y medianos empresarios de la cadena láctea cordobesa, quienes podrán mejorar significativamente la inocuidad de sus productos tradicionales.
“Hemos compartido todas las tecnologías que desarrolla nuestro grupo de investigación con estos productores, porque nuestro compromiso es con la región y con la mejora de la calidad de los productos autóctonos”, explicó la docente investigadora Maryoris Soto López, del Grupo de Investigación en Procesos y Propiedades Alimentarias (GIPPAL), clasificado en Categoría A por MinCiencias.
La transferencia tecnológica incluye el suministro del producto encapsulado junto a instrucciones precisas de dosificación, facilitando su aplicación en los procesos productivos artesanales e industriales. El virus, que combate las bacterias Escherichia coli y Salmonella, extiende la vida útil del queso costeño mientras preserva sus características nutricionales y organolépticas.

El profesor Omar Pérez Sierra, coautor de la investigación, destacó que el bioproducto se alimenta de las bacterias patógenas, secuestrando su maquinaria celular para replicarse y perdurar en el tiempo, ofreciendo una protección sostenida sin alterar las propiedades del queso tradicional.
Este proyecto, financiado conjuntamente por Unicórdoba y MinCiencias, representa 15 años de trabajo sostenido del GIPPAL y consolida al departamento de Córdoba como referente nacional en investigación aplicada al sector agroalimentario, beneficiando directamente a las familias que dependen de la producción quesera en la región.









